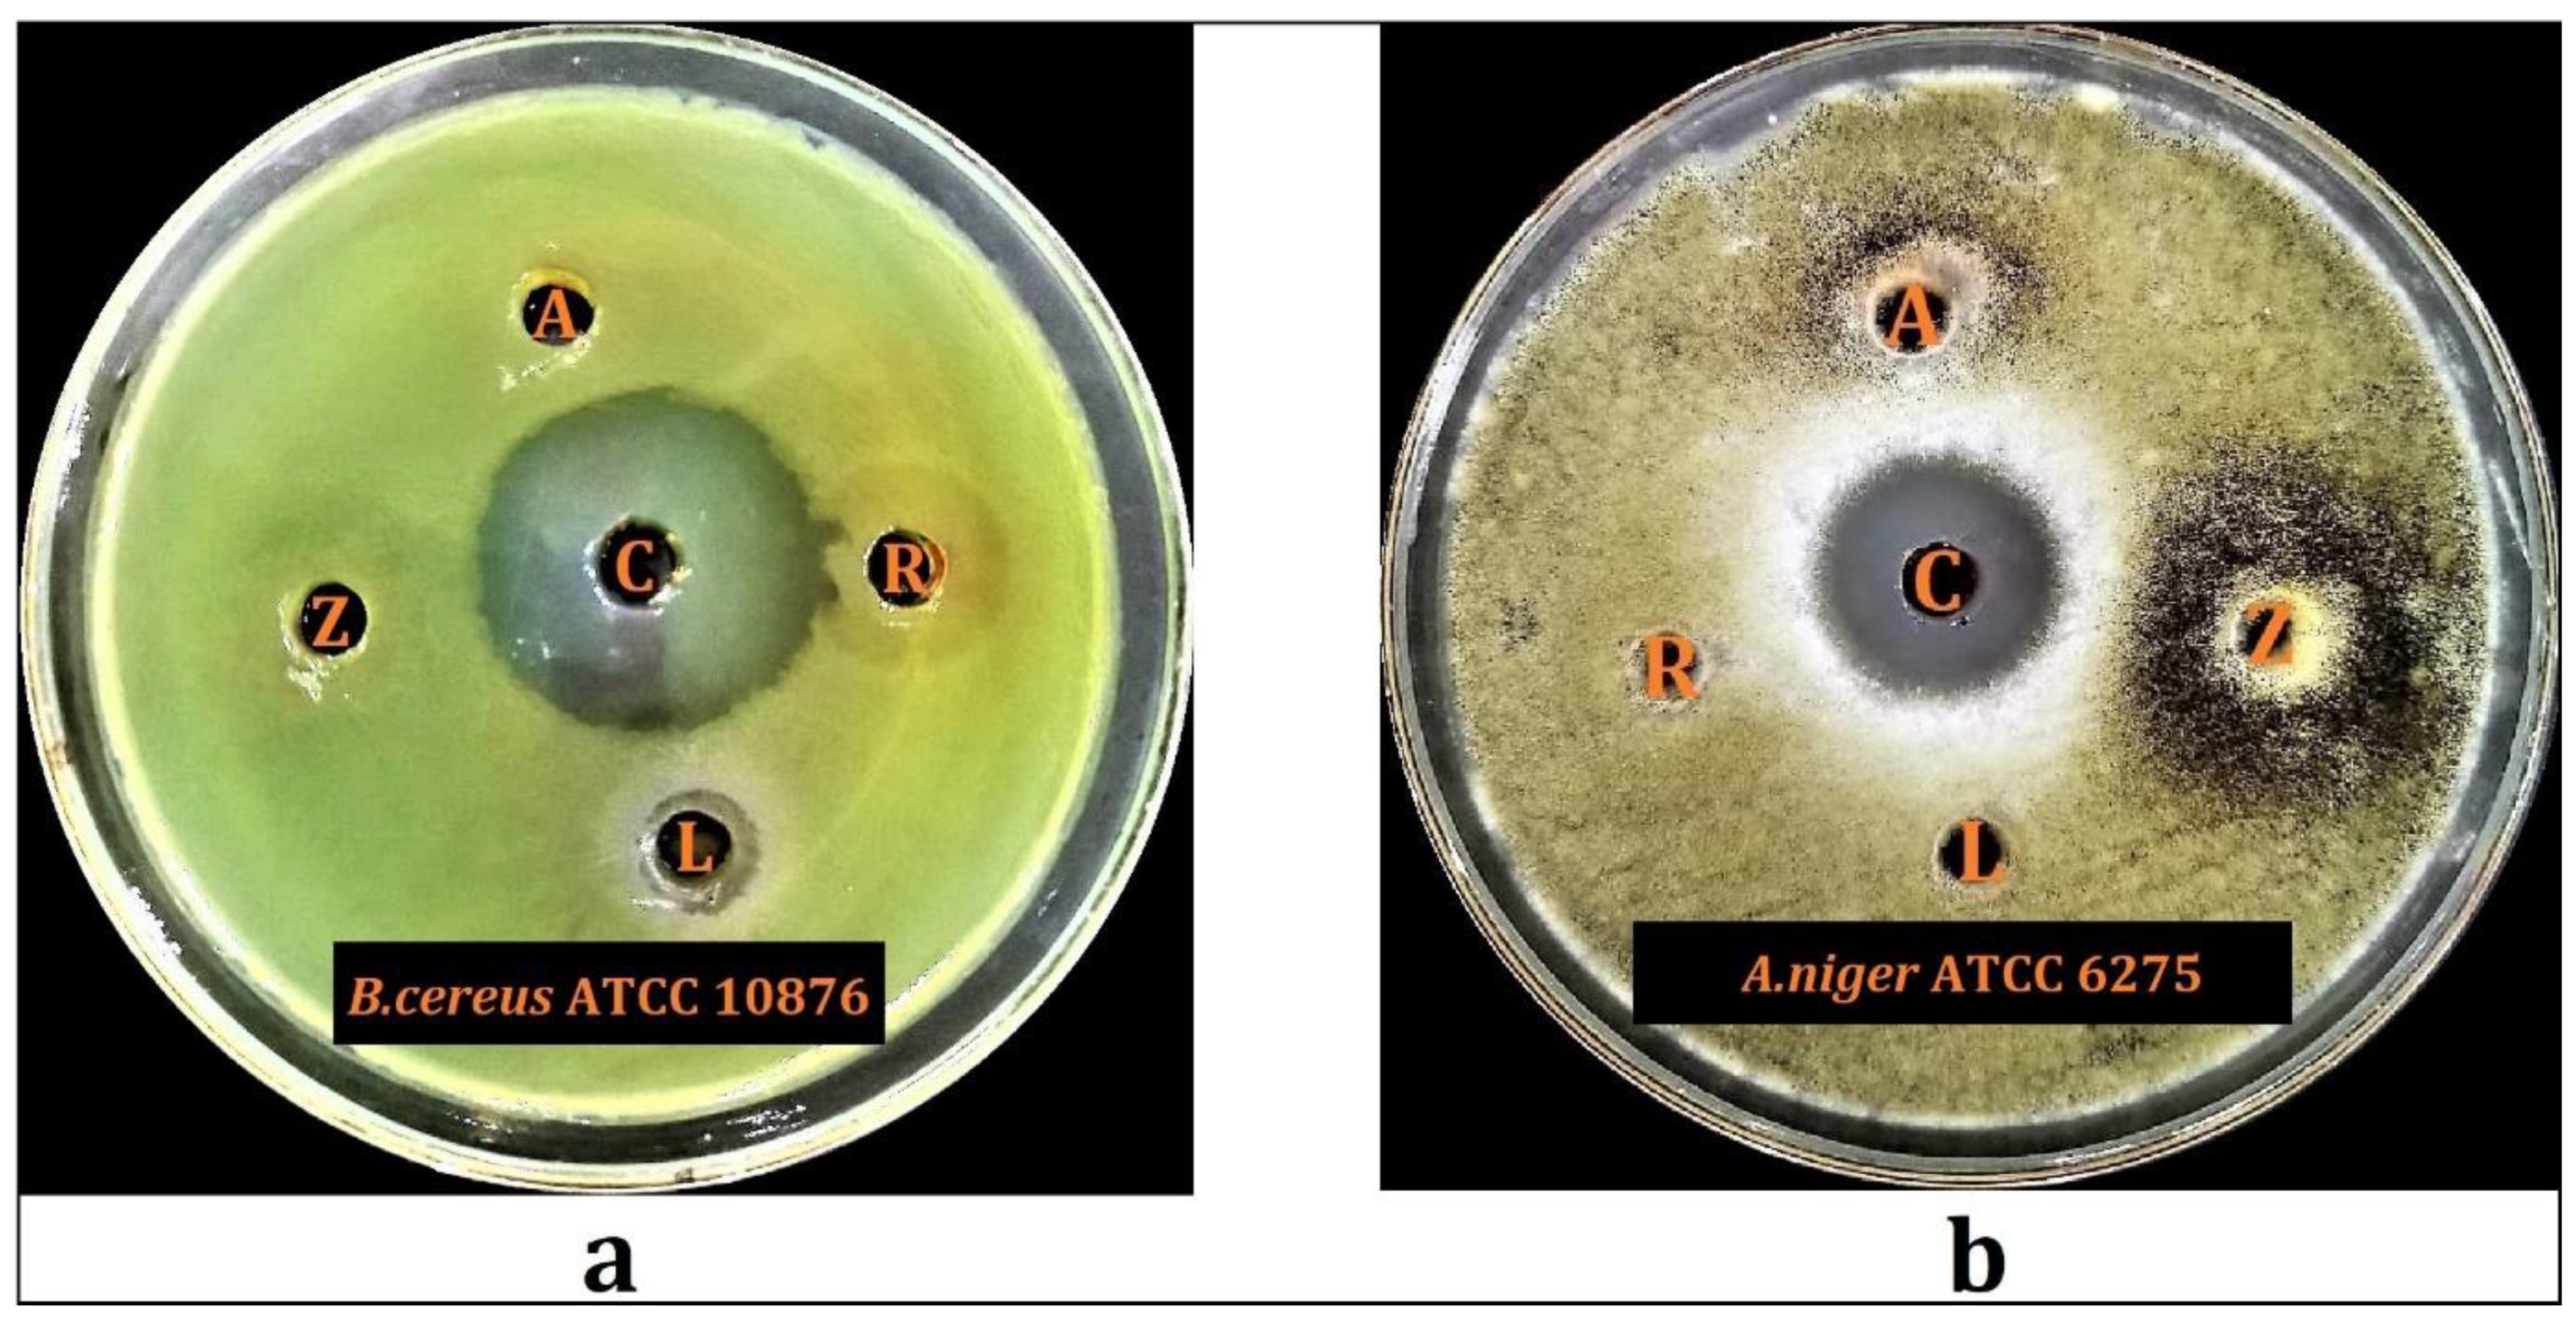
Plants 10 02208 g005

Comparative Phytochemical Profile and Biological Activity of Four Major Medicinal Halophytes from Qassim Flora
Abstract
:1. Introduction
2. Results and Discussion
2.1. Trace Elements Analysis
2.2. LC-MS Profiles of the Plants
2.3. Total Phenolic and Flavonoid Contents
2.4. Antioxidant Activity
2.5. Cytotoxicity Analysis
2.6. Antimicrobial Activity
2.6.1. Preliminary Antimicrobial Screening
2.6.2. Minimum Inhibitory Concentration and Minimum Bacterial Concentration
2.7. Plants’ Antioxidant Potential, Biological Activity, Flavonoids Plausible Biogenetic Interrelationships, and Molecular Oxygen Proliferations
3. Materials and Methods
3.1. Plant Materials and Extractions
3.2. Liquid Chromatography-Mass Spectroscopy (LC-MS) Analysis
3.3. Quantitative Measurements of the Total Phenolics and Flavonoids Contents
3.4. Trace Elements Analysis
3.5. Antioxidant Activity
3.5.1. Total Antioxidant Capacity
3.5.2. DPPH Scavenging Activity
3.5.3. Ferric Reducing Antioxidant Power (FRAP) Assay
3.5.4. Metal Chelating Activity Assay
3.6. Cytotoxic Assay
3.7. Apoptotic Assay
3.8. Antimicrobial Evaluations
3.8.1. Test Organisms
3.8.2. Antimicrobial Activity
Preliminary Antimicrobial Activity
MIC and MBC
3.9. Statistical Analysis
4. Conclusions
Supplementary Materials
Author Contributions
Funding
Institutional Review Board Statement
Informed Consent Statement
Data Availability Statement
Acknowledgments
Conflicts of Interest
References
- Jamshidi-Kia, F.; Lorigooini, Z.; Amini-Khoei, H. Medicinal plants: Past history and future perspective. J. Herbmed Pharmacol. 2018, 7, 1–7. [Google Scholar] [CrossRef]
- Johns, T. The Origins of Human Diet and Medicine: Chemical Ecology; University of Arizona Press: Tucson, AZ, USA, 1996; ISBN 0816516871. [Google Scholar]
- Farnsworth, N.R.; Soejarto, D.D. Global importance of medicinal plants. Conserv. Med. plants 1991, 26, 25–51. [Google Scholar]
- Gurib-Fakim, A. Medicinal plants: Traditions of yesterday and drugs of tomorrow. Mol. Aspects Med. 2006, 27, 1–93. [Google Scholar] [CrossRef]
- Alamgir, A.N.M. Pharmacognostical Botany: Classification of medicinal and aromatic plants (MAPs), botanical taxonomy, morphology, and anatomy of drug plants. In Therapeutic Use of Medicinal Plants and Their Extracts; Springer: Berlin/Heidelberg, Germany, 2017; Volume 1, pp. 177–293. [Google Scholar]
- Sasidharan, S.; Saudagar, P. Plant metabolites as new leads to drug discovery. In Natural Bio-Active Compounds; Springer: Berlin/Heidelberg, Germany, 2019; pp. 275–295. [Google Scholar]
- Anywar, G. Historical Use of Toxic Plants. Poisonous Plants Phytochem. Drug Discov. 2020, 1–17. [Google Scholar] [CrossRef]
- Yadesa, T.M.; Ogwang, P.E.; Tolo, C.U. Drugs in Clinical Practice from Toxic Plants and Phytochemicals. Poisonous Plants Phytochem. Drug Discov. 2020, 79–94. [Google Scholar] [CrossRef]
- Koparde, A.A.; Doijad, R.C.; Magdum, C.S. Natural products in drug discovery. In Pharmacognosy: Medicinal Plants; BoD–Books on Demand: Norderstedt, Germany, 2019; pp. 1–20. [Google Scholar]
- Egbuna, C.; Kumar, S.; Ifemeje, J.C.; Ezzat, S.M.; Kaliyaperumal, S. Phytochemicals as Lead Compounds for New Drug Discovery; Elsevier: Amsterdam, The Netherlands, 2019; ISBN 0128178914. [Google Scholar]
- Nazish, M.; Zafar, M.; Ahmad, M.; Sultana, S. Halophyte Diversity in Pakistan: Wild Resources and Their Ethnobotanical Significance. In Handbook of Halophytes; Springer: Cham, Switzerland, 2020; pp. 1–24. [Google Scholar] [CrossRef]
- Al-Omar, M.S.; Mohammed, H.A.; Mohammed, S.A.A.; Abd-Elmoniem, E.; Kandil, Y.I.; Eldeeb, H.M.; Chigurupati, S.; Sulaiman, G.M.; Al-Khurayyif, H.K.; Almansour, B.S. Anti-Microbial, Anti-Oxidant, and α-Amylase Inhibitory Activity of Traditionally-Used Medicinal Herbs: A Comparative Analyses of Pharmacology, and Phytoconstituents of Regional Halophytic Plants’ Diaspora. Molecules 2020, 25, 5457. [Google Scholar] [CrossRef] [PubMed]
- Ishtiyaq, S.; Kumar, H.; Varun, M.; Ogunkunle, C.O.; Paul, M.S. Role of secondary metabolites in salt and heavy metal stress mitigation by halophytic plants: An overview. Handb. Bioremediation 2021, 307–327. [Google Scholar] [CrossRef]
- Mohammed, H.A. The Valuable Impacts of Halophytic Genus Suaeda; Nutritional, Chemical, and Biological Values. Med. Chem. 2020, 16, 1044–1057. [Google Scholar] [CrossRef]
- Mohammed, H.A.; Al-Omar, M.S.; Mohammed, S.A.A.; Alhowail, A.H.; Eldeeb, H.M.; Sajid, M.S.M.; Abd-Elmoniem, E.M.; Alghulayqeh, O.A.; Kandil, Y.I.; Khan, R.A. Phytochemical Analysis, Pharmacological and Safety Evaluations of Halophytic Plant, Salsola cyclophylla. Molecules 2021, 26, 2384. [Google Scholar] [CrossRef]
- Stevanovic, Z.D.; Stankovic, M.S.; Stankovic, J.; Janackovic, P.; Stankovic, M. Use of Halophytes as Medicinal Plants: Phytochemical Diversity and Biological Activity. In Halophytes and Climate Change: Adaptive Mechanisms and Potential Uses; CABI: Wallingford, UK, 2019; p. 343. [Google Scholar]
- Elhag, M. Evaluation of different soil salinity mapping using remote sensing techniques in arid ecosystems, Saudi Arabia. J. Sens. 2016, 2016, 7596175. [Google Scholar] [CrossRef] [Green Version]
- Mohammed, H.A.; Al-Omar, M.S.; Khan, R.A.; Mohammed, S.A.A.; Qureshi, K.A.; Abbas, M.M.; Al Rugaie, O.; Abd-Elmoniem, E.; Ahmad, A.M.; Kandil, Y.I. Chemical Profile, Antioxidant, Antimicrobial, and Anticancer Activities of the Water-Ethanol Extract of Pulicaria undulata Growing in the Oasis of Central Saudi Arabian Desert. Plants 2021, 10, 1811. [Google Scholar] [CrossRef]
- Jithesh, M.N.; Prashanth, S.R.; Sivaprakash, K.R.; Parida, A.K. Antioxidative response mechanisms in halophytes: Their role in stress defence. J. Genet. 2006, 85, 237. [Google Scholar] [CrossRef]
- Benjamin, J.J.; Lucini, L.; Jothiramshekar, S.; Parida, A. Metabolomic insights into the mechanisms underlying tolerance to salinity in different halophytes. Plant Physiol. Biochem. 2019, 135, 528–545. [Google Scholar] [CrossRef]
- Khdery, G.A.; Farg, E.; Arafat, S.M. Natural vegetation cover analysis in Wadi Hagul, Egypt using hyperspectral remote sensing approach. Egypt. J. Remote Sens. Sp. Sci. 2019, 22, 253–262. [Google Scholar] [CrossRef]
- Baharav, D. Desert habitat partitioning by the dorcas gazelle. J. Arid Environ. 1982, 5, 323–335. [Google Scholar] [CrossRef]
- Rahman, M.A.; Mossa, J.S.; Al-Said, M.S.; Al-Yahya, M.A. Medicinal plant diversity in the flora of Saudi Arabia 1: A report on seven plant families. Fitoterapia 2004, 75, 149–161. [Google Scholar] [CrossRef]
- Mishra, A.P.; Sharifi-Rad, M.; Shariati, M.A.; Mabkhot, Y.N.; Al-Showiman, S.S.; Rauf, A.; Salehi, B.; Župunski, M.; Sharifi-Rad, M.; Gusain, P. Bioactive compounds and health benefits of edible Rumex species-A review. Cell. Mol. Biol. 2018, 64, 27–34. [Google Scholar] [CrossRef] [Green Version]
- Hamza, N.; Berke, B.; Umar, A.; Cheze, C.; Gin, H.; Moore, N. A review of Algerian medicinal plants used in the treatment of diabetes. J. Ethnopharmacol. 2019, 238, 111841. [Google Scholar] [CrossRef]
- El-Shabasy, A. Survey on medicinal plants in the flora of Jizan Region, Saudi Arabia. Int. J. Bot. Stud. 2016, 2, 38–59. [Google Scholar]
- Al-Qahtani, H.; Alfarhan, A.H.; Al-Othman, Z.M. Changes in chemical composition of Zilla spinosa Forssk. medicinal plants grown in Saudi Arabia in response to spatial and seasonal variations. Saudi J. Biol. Sci. 2020, 27, 2756–2769. [Google Scholar] [CrossRef]
- Ahmed, A.S. Biological Activities of Extracts and Isolated Compounds from Bauhinia Galpinii (Fabaceae) and Combretum Vendae (Combretaceae) as Potential Antidiarrhoeal Agents. Ph.D. Thesis, University of Pretoria, Pretoria, South Africa, 2012. [Google Scholar]
- Attar, T. A mini-review on importance and role of trace elements in the human organism. Chem. Rev. Lett. 2020, 3, 117–130. [Google Scholar]
- Skalny, A.V. Bioelements and bioelementology in pharmacology and nutrition: Fundamental and practical aspects. In Pharmacology and Nutritional Intervention in the Treatment of Disease; InTech: Rijeka, Croatia, 2014; pp. 225–241. [Google Scholar]
- Agudelo, A.; Carvajal, M.; del C. Martinez-Ballesta, M. Halophytes of the Mediterranean Basin—Underutilized Species with the Potential to Be Nutritious Crops in the Scenario of the Climate Change. Foods 2021, 10, 119. [Google Scholar] [CrossRef] [PubMed]
- Hanan, Z.; Ibrahim, N.H.; Donia, G.R.; Younis, F.E.; Shaker, Y.M. Scrutinizing of trace elements and antioxidant enzymes changes in Barki ewes fed salt-tolerant plants under South Sinai conditions. J. Am. Sci. 2014, 10, 54–62. [Google Scholar]
- Padayatty, S.; Espey, M.G.; Levine, M.; Vitamin, C. Encyclopedia of Dietary Supplements; CRC Press: Boca Raton, FL, USA, 2010. [Google Scholar]
- Del Gobbo, L.C.; Imamura, F.; Wu, J.H.Y.; de Oliveira Otto, M.C.; Chiuve, S.E.; Mozaffarian, D. Circulating and dietary magnesium and risk of cardiovascular disease: A systematic review and meta-analysis of prospective studies. Am. J. Clin. Nutr. 2013, 98, 160–173. [Google Scholar] [CrossRef] [Green Version]
- Aschner, J.L.; Aschner, M. Nutritional aspects of manganese homeostasis. Mol. Aspects Med. 2005, 26, 353–362. [Google Scholar] [CrossRef]
- Aschner, M.; Erikson, K.M.; Dorman, D.C. Manganese dosimetry: Species differences and implications for neurotoxicity. Crit. Rev. Toxicol. 2005, 35, 1–32. [Google Scholar] [CrossRef] [PubMed]
- Ganz, T. Systemic iron homeostasis. Physiol. Rev. 2013, 93, 1721–1741. [Google Scholar] [CrossRef] [PubMed] [Green Version]
- Casiday, R.; Frey, R. Iron Use and Storage in the Body: Ferritin and Molecular Representations; Department of Chemistry, Washington University: St. Louis, MI, USA, 1998. [Google Scholar]
- Lobo, V.; Patil, A.; Phatak, A.; Chandra, N. Free radicals, antioxidants and functional foods: Impact on human health. Pharmacogn. Rev. 2010, 4, 118. [Google Scholar] [CrossRef] [PubMed] [Green Version]
- Malavé, I.; Rodriguez, J.; Araujo, Z.; Rojas, I. Effect of zinc on the proliferation response of human lymphocytes: Mechanism of its mitogenic action. Immunopharmacology 1990, 20, 1–10. [Google Scholar] [CrossRef]
- Attar, T.; Harek, Y.; Larabi, L. Determination of ultra trace levels of copper in whole blood by adsorptive stripping voltammetry. J. Korean Chem. Soc. 2013, 57, 568–573. [Google Scholar] [CrossRef] [Green Version]
- Haase, H.; Rink, L. Multiple impacts of zinc on immune function. Metallomics 2014, 6, 1175–1180. [Google Scholar] [CrossRef] [PubMed]
- Watson, T.D.G. Diet and skin disease in dogs and cats. J. Nutr. 1998, 128, 2783S–2789S. [Google Scholar] [CrossRef] [PubMed] [Green Version]
- Islam, M.R.; Attia, J.; Ali, L.; McEvoy, M.; Selim, S.; Sibbritt, D.; Akhter, A.; Akter, S.; Peel, R.; Faruque, O. Zinc supplementation for improving glucose handling in pre-diabetes: A double blind randomized placebo controlled pilot study. Diabetes Res. Clin. Pract. 2016, 115, 39–46. [Google Scholar] [CrossRef]
- Zhang, Y.; Gladyshev, V.N. Comparative genomics of trace elements: Emerging dynamic view of trace element utilization and function. Chem. Rev. 2009, 109, 4828–4861. [Google Scholar] [CrossRef]
- Takahashi-Iñiguez, T.; García-Hernandez, E.; Arreguín-Espinosa, R.; Flores, M.E. Role of vitamin B 12 on methylmalonyl-CoA mutase activity. J. Zhejiang Univ. Sci. B 2012, 13, 423–437. [Google Scholar] [CrossRef] [PubMed] [Green Version]
- Banerjee, R.; Vlasie, M. Controlling the reactivity of radical intermediates by coenzyme B12-dependent methylmalonyl-CoA mutase. Biochem. Soc. Trans. 2002, 30, 621–624. [Google Scholar] [CrossRef] [Green Version]
- Saker, F.; Ybarra, J.; Leahy, P.; Hanson, R.W.; Kalhan, S.C.; Ismail-Beigi, F. Glycemia-lowering effect of cobalt chloride in the diabetic rat: Role of decreased gluconeogenesis. Am. J. Physiol. Metab. 1998, 274, E984–E991. [Google Scholar] [CrossRef]
- L’Abbate, A.; Neglia, D.; Vecoli, C.; Novelli, M.; Ottaviano, V.; Baldi, S.; Barsacchi, R.; Paolicchi, A.; Masiello, P.; Drummond, G.S. Beneficial effect of heme oxygenase-1 expression on myocardial ischemia-reperfusion involves an increase in adiponectin in mildly diabetic rats. Am. J. Physiol. Circ. Physiol. 2007, 293, H3532–H3541. [Google Scholar] [CrossRef] [Green Version]
- Kelly, F.D.; Sinclair, A.J.; Mann, N.J.; Turner, A.H.; Abedin, L.; Li, D. A stearic acid-rich diet improves thrombogenic and atherogenic risk factor profiles in healthy males. Eur. J. Clin. Nutr. 2001, 55, 88–96. [Google Scholar] [CrossRef] [Green Version]
- Patel, M.K.; Pandey, S.; Brahmbhatt, H.R.; Mishra, A.; Jha, B. Lipid content and fatty acid profile of selected halophytic plants reveal a promising source of renewable energy. Biomass Bioenergy 2019, 124, 25–32. [Google Scholar] [CrossRef]
- Vizetto-Duarte, C.; Figueiredo, F.; Rodrigues, M.J.; Polo, C.; Rešek, E.; Custódio, L. Sustainable Valorization of Halophytes from the Mediterranean Area: A Comprehensive Evaluation of Their Fatty Acid Profile and Implications for Human and Animal Nutrition. Sustainability 2019, 11, 2197. [Google Scholar] [CrossRef] [Green Version]
- Jaganath, I.B.; Crozier, A. Dietary flavonoids and phenolic compounds. Plant Phenolics Hum. Health Biochem. Nutr. Pharmacol. 2010, 1, 1–50. [Google Scholar]
- Fraga, C.G. Plant Phenolics and Human Health: Biochemistry, Nutrition and Pharmacology; John Wiley & Sons: Hoboken, NJ, USA, 2010. [Google Scholar]
- Mohammed, H.A.; Khan, R.A.; Abdel-Hafez, A.A.; Abdel-Aziz, M.; Ahmed, E.; Enany, S.; Mahgoub, S.; Al-Rugaie, O.; Alsharidah, M.; Aly, M.S.A. Phytochemical Profiling, In Vitro and In Silico Anti-Microbial and Anti-Cancer Activity Evaluations and Staph GyraseB and h-TOP-IIβ Receptor-Docking Studies of Major Constituents of Zygophyllum coccineum L. Aqueous-Ethanolic Extract and Its Subsequent Fra. Molecules 2021, 26, 577. [Google Scholar] [CrossRef] [PubMed]
- Rigane, G.; Ghazghazi, H.; Aouadhi, C.; Ben Salem, R.; Nasr, Z. Phenolic content, antioxidant capacity and antimicrobial activity of leaf extracts from Pistacia atlantica. Nat. Prod. Res. 2017, 31, 696–699. [Google Scholar] [CrossRef]
- Raffa, D.; Maggio, B.; Raimondi, M.V.; Plescia, F.; Daidone, G. Recent discoveries of anticancer flavonoids. Eur. J. Med. Chem. 2017, 142, 213–228. [Google Scholar] [CrossRef]
- Shahidi, F.; Yeo, J. Bioactivities of phenolics by focusing on suppression of chronic diseases: A review. Int. J. Mol. Sci. 2018, 19, 1573. [Google Scholar] [CrossRef] [Green Version]
- Al-Snafi, A.E. Phenolics and flavonoids contents of medicinal plants, as natural ingredients for many therapeutic purposes—A review. IOSR J. Pharm. 2020, 10, 42–81. [Google Scholar]
- Agrawal, A.D. Pharmacological activities of flavonoids: A review. Int. J. Pharm. Sci. Nanotechnol. 2011, 4, 1394–1398. [Google Scholar]
- Croft, K.D. The chemistry and biological effects of flavonoids and phenolic acids a. Ann. N. Y. Acad. Sci. 1998, 854, 435–442. [Google Scholar] [CrossRef] [PubMed]
- Maalik, A.; Khan, F.A.; Mumtaz, A.; Mehmood, A.; Azhar, S.; Atif, M.; Karim, S.; Altaf, Y.; Tariq, I. Pharmacological applications of quercetin and its derivatives: A short review. Trop. J. Pharm. Res. 2014, 13, 1561–1566. [Google Scholar] [CrossRef]
- Sezer, E.D.; Oktay, L.M.; Karadadaş, E.; Memmedov, H.; Selvi Gunel, N.; Sözmen, E. Assessing anticancer potential of blueberry flavonoids, quercetin, kaempferol, and gentisic acid, through oxidative stress and apoptosis parameters on HCT-116 cells. J. Med. Food 2019, 22, 1118–1126. [Google Scholar] [CrossRef]
- Smiljkovic, M.; Stanisavljevic, D.; Stojkovic, D.; Petrovic, I.; Vicentic, J.M.; Popovic, J.; Grdadolnik, S.G.; Markovic, D.; Sankovic-Babice, S.; Glamoclija, J. Apigenin-7-O-glucoside versus apigenin: Insight into the modes of anticandidal and cytotoxic actions. EXCLI J. 2017, 16, 795. [Google Scholar] [PubMed]
- Daglia, M. Polyphenols as antimicrobial agents. Curr. Opin. Biotechnol. 2012, 23, 174–181. [Google Scholar] [CrossRef]
- Nile, A.; Nile, S.H.; Cespedes, C.L.; Oh, J.-W. Spiraeoside extracted from red onion skin ameliorates apoptosis and exerts potent antitumor, antioxidant and enzyme inhibitory effects. Food Chem. Toxicol. 2021, 154, 112327. [Google Scholar] [CrossRef] [PubMed]
- Vaiyapuri, M.; Natesan, K.; Vasamsetti, B.M.K.; Mekapogu, M.; Swamy, M.K.; Thangaraj, K. Orientin: A C-Glycosyl Flavonoid that Mitigates Colorectal Cancer. In Plant-Derived Bioactives; Springer: Berlin/Heidelberg, Germany, 2020; pp. 1–19. [Google Scholar]
- Goodarzi, S.; Tabatabaei, M.J.; Mohammad Jafari, R.; Shemirani, F.; Tavakoli, S.; Mofasseri, M.; Tofighi, Z. Cuminum cyminum fruits as source of luteolin-7-O-glucoside, potent cytotoxic flavonoid against breast cancer cell lines. Nat. Prod. Res. 2020, 34, 1602–1606. [Google Scholar] [CrossRef]
- Ganesan, K.; Xu, B. Molecular targets of vitexin and isovitexin in cancer therapy: A critical review. Ann. N. Y. Acad. Sci. 2017, 1401, 102–113. [Google Scholar] [CrossRef]
- Panche, A.N.; Diwan, A.D.; Chandra, S.R. Flavonoids: An overview. J. Nutr. Sci. 2016, 5, E47. [Google Scholar] [CrossRef] [PubMed] [Green Version]
- Beddou, F.; Bekhechi, C.; Ksouri, R.; Sari, D.C.; Bekkara, F.A. Potential assessment of Rumex vesicarius L. as a source of natural antioxidants and bioactive compounds. J. Food Sci. Technol. 2015, 52, 3549–3560. [Google Scholar] [CrossRef] [Green Version]
- Alharbi, K.B.; Mousa, H.M.; Ibrahim, Z.H.; El-Ashmawy, I.M. Hepatoprotective effect of methanolic extracts of Prosopis farcta and Lycium shawii against carbon tetrachloride-induced hepatotoxicity in rats. J. Biol. Sci. 2017, 17, 35–41. [Google Scholar] [CrossRef] [Green Version]
- Suleiman, M.H.A.; Ateeg, A.A. Antimicrobial and Antioxidant Activities of Different Extracts from Different Parts of Zilla spinosa (L.) Prantl. Evid.-Based Complement. Altern. Med. 2020, 2020, 6690433. [Google Scholar] [CrossRef]
- Zeb, A. Concept, mechanism, and applications of phenolic antioxidants in foods. J. Food Biochem. 2020, 44, e13394. [Google Scholar] [CrossRef]
- Karak, P. Biological activities of flavonoids: An overview. Int. J. Pharm. Sci. Res. 2019, 10, 1567–1574. [Google Scholar]
- Kosanić, M.; Ranković, B.; Stanojković, T.; Rančić, A.; Manojlović, N. Cladonia lichens and their major metabolites as possible natural antioxidant, antimicrobial and anticancer agents. LWT-Food Sci. Technol. 2014, 59, 518–525. [Google Scholar] [CrossRef]
- Dahech, I.; Farah, W.; Trigui, M.; Hssouna, A.B.; Belghith, H.; Belghith, K.S.; Abdallah, F.B. Antioxidant and antimicrobial activities of Lycium shawii fruits extract. Int. J. Biol. Macromol. 2013, 60, 328–333. [Google Scholar] [CrossRef]
- Mothana, R.A.A.; Kriegisch, S.; Harms, M.; Wende, K.; Lindequist, U. Assessment of selected Yemeni medicinal plants for their in vitro antimicrobial, anticancer, and antioxidant activities. Pharm. Biol. 2011, 49, 200–210. [Google Scholar] [CrossRef] [PubMed]
- Akbar, S.; Al-Yahya, M.A. Screening of Saudi plants for phytoconstituents, pharmacological and antimicrobial properties. Aust. J. Med. Herbal. 2011, 23, 76–87. [Google Scholar]
- Do, Q.D.; Angkawijaya, A.E.; Tran-Nguyen, P.L.; Huynh, L.H.; Soetaredjo, F.E.; Ismadji, S.; Ju, Y.-H. Effect of extraction solvent on total phenol content, total flavonoid content, and antioxidant activity of Limnophila aromatica. J. Food Drug. Anal. 2014, 22, 296–302. [Google Scholar] [CrossRef] [PubMed] [Green Version]
- Johnsson, L. Selenium uptake by plants as a function of soil type, organic matter content and pH. Plant Soil 1991, 133, 57–64. [Google Scholar] [CrossRef]
- Aroua, L.M.; Almuhaylan, H.R.; Alminderej, F.M.; Messaoudi, S.; Chigurupati, S.; Al-Mahmoud, S.; Mohammed, H.A. A facile approach synthesis of benzoylaryl benzimidazole as potential α-amylase and α-glucosidase inhibitor with antioxidant activity. Bioorg. Chem. 2021, 114, 105073. [Google Scholar] [CrossRef]
- Shimada, K.; Fujikawa, K.; Yahara, K.; Nakamura, T. Antioxidative properties of xanthan on the autoxidation of soybean oil in cyclodextrin emulsion. J. Agric. Food Chem. 1992, 40, 945–948. [Google Scholar] [CrossRef]
- Benzie, I.F.F.; Strain, J.J. The ferric reducing ability of plasma (FRAP) as a measure of “antioxidant power”: The FRAP assay. Anal. Biochem. 1996, 239, 70–76. [Google Scholar] [CrossRef] [PubMed] [Green Version]
- Zengin, G.; Nithiyanantham, S.; Locatelli, M.; Ceylan, R.; Uysal, S.; Aktumsek, A.; Selvi, P.K.; Maskovic, P. Screening of in vitro antioxidant and enzyme inhibitory activities of different extracts from two uninvestigated wild plants: Centranthus longiflorus subsp. longiflorus and Cerinthe minor subsp. auriculata. Eur. J. Integr. Med. 2016, 8, 286–292. [Google Scholar] [CrossRef]
- Balouiri, M.; Sadiki, M.; Ibnsouda, S.K. Methods for in vitro evaluating antimicrobial activity: A review. J. Pharm. Anal. 2016, 6, 71–79. [Google Scholar] [CrossRef] [PubMed] [Green Version]
- Qureshi, K.A.; Elhassan, G.O. Isolation, Purification and Characterization of Antimicrobial Agent Antagonistic to Escherichia coli ATCC 10536 Produced by Bacillus pumilus SAFR-032 Isolated from the Soil of Unaizah, Al Qassim Province of Saudi Arabia. Pak. J. Biol. Sci. 2016, 19, 191. [Google Scholar] [CrossRef]
- Elshikh, M.; Ahmed, S.; Funston, S.; Dunlop, P.; McGaw, M.; Marchant, R.; Banat, I.M. Resazurin-based 96-well plate microdilution method for the determination of minimum inhibitory concentration of biosurfactants. Biotechnol. Lett. 2016, 38, 1015–1019. [Google Scholar] [CrossRef] [Green Version]
- Schwalbe, R.; Steele-Moore, L.; Goodwin, A.C. Antimicrobial Susceptibility Testing Protocols; CRC Press: Boca Raton, FL, USA, 2007; ISBN 1420014498. [Google Scholar]

| Elements | Lycium shawii | Anabasis articulata | Rumex vesicarius | Zilla spinosa |
|---|---|---|---|---|
| Fe | 12.33 ± 4.16 | 24.33 ± 2.08 | 16.67 ± 2.31 | 93.47 ± 1.16 |
| Cu | 10.34 ± 2.11 | 13.67 ± 0.50 | 10.96 ± 0.93 | 10.44 ± 0.95 |
| Mn | 28.53 ± 0.42 | 39.1 ± 0.85 | 96.03 ± 1.04 | 34.8 ± 0.36 |
| Co | 15.67 ± 4.07 | 14.07 ± 1.31 | 18.0 ± 3.55 | 12.23 ± 2.07 |
| Zn | 12.93 ± 1.34 | 44.63 ± 0.40 | 109 ± 0.00 | 10.52 ± 1.10 |
| Mg | 1163 ± 9.17 | 1272 ± 18.52 | 1250 ± 20.0 | 1191 ± 10.14 |
| Sr | RT (min) | Observed Mass (m/z) | Calcd. Mass (m/z) | Ion | Molecular Formula | Identity * | Relative % of the Identified Compounds ** | |||
|---|---|---|---|---|---|---|---|---|---|---|
| R. vesicarius | L. shawii | A. articulata | Z. spinosa | |||||||
| 1 | 0.54 | 181.0721 | 182.0794 | [M-H]- | Sorbitol | C6H14O6 | 0.0859 | 0.0358 | 0.0008 | 0.0013 |
| 2 | 0.55 | 341.1070 | 342.1138 | [M-H]- | Hexose-based disaccharide | C12H22O11 | 2.7116 | 4.0265 | 0.1345 | 0.2199 |
| 3 | 0.55 | 683.2218 | 684.2291 | [M-H]- | Galabiose | C24H44O22 | 0.0262 | 0.0818 | ||
| 4 | 1.00 | 202.1069 | 203.1142 | [M-H]- | L-Acetyl carnitine | C9H17NO4 | 0.0260 | 0.0053 | 0.0003 | 0.0006 |
| 5 | 2.21 | 165.0533 | 166.0606 | [M-H]- | 3-Phenyl lactic acid | C9H10O3 | 0.1023 | 0.0013 | ||
| 6 | 2.95 | 353.0859 | 354.0931 | [M-H]- | Chlorogenic acid | C16H18O9 | 0.4393 | 0.0056 | ||
| 7 | 4.72 | 387.1985 | 388.2058 | [M-H]- | 5-Methoxy-7,8-diprenylflavone | C26H28O3 | 0.0005 | 0.0007 | 0.0004 | |
| 8 | 4.76 | 471.1875 | 472.1947 | [M-H]- | Eugenol rutinoside | C22H32O11 | 0.0010 | 0.0014 | 0.0006 | |
| 9 | 4.89 | 463.0886 | 464.0959 | [M-H]- | Spiraeoside | C21H20O12 | 0.0005 | |||
| 10 | 4.95 | 447.0890 | 448.0963 | [M-H]- | Orientin | C21H20O11 | 0.0021 | 0.0003 | 0.0002 | |
| 11 | 5.54 | 593.1488 | 594.1560 | [M-H]- | Quercetin-3,7-dirhamnosyl | C27H30O15 | 0.0311 | 0.0118 | 0.0006 | 0.0011 |
| 12 | 5.60 | 609.1427 | 610.1500 | [M-H]- | 3-Gluco-7-rhamnosyl quercetin | C27H30O16 | 0.0050 | 1.3642 | 0.0069 | 0.0346 |
| 13 | 5.73 | 463.0861 | 464.0934 | [M-H]- | Hyperoside | C21H20O12 | 0.2741 | 0.0087 | 0.0003 | |
| 14 | 5.92 | 447.0906 | 448.0978 | [M-H]- | Luteolin 7-O-glucoside | C21H20O11 | 0.0054 | 0.1352 | ||
| 15 | 6.32 | 577.1539 | 578.1625 | [M-H]- | Isorhoifolin | C27H30O14 | 0.0406 | 0.0123 | ||
| 16 | 6.36 | 593.1472 | 594.1545 | [M-H]- | Kaempferol 3-neohesperidosid | C27H30O15 | 0.0008 | 1.5347 | 0.0328 | 0.2967 |
| 17 | 6.57 | 447.0918 | 448.0991 | [M-H]- | Kaempferol-3-O-glucoside | C21H20O11 | 0.2531 | 0.0081 | ||
| 18 | 6.81 | 285.0402 | 286.0475 | [M-H]- | 3,6,2’,4’-Tetrahydroxyflavone | C15H10O6 | 0.0053 | |||
| 19 | 6.81 | 447.0935 | 448.1008 | [M-H]- | Luteolin-4’-O-glucoside | C21H20O11 | 0.0010 | 0.0211 | ||
| 20 | 6.82 | 431.0962 | 432.1035 | [M-H]- | Vitexin | C21H20O10 | 0.0031 | 0.0351 | 0.0013 | |
| 21 | 6.90 | 431.0985 | 432.1058 | [M-H]- | Isovitexin | C21H20O10 | 0.0006 | 0.0543 | 0.0002 | |
| 22 | 7.76 | 829.2216 | 830.2289 | [M-H]- | Alatanin | C39H42O20 | 0.0052 | 0.0007 | ||
| 23 | 7.77 | 289.1097 | 290.1169 | [M-H]- | 5-O-Methylvisamminol | C16H18O5 | 0.0307 | 0.8107 | 0.0879 | |
| 24 | 8.06 | 312.1217 | 313.1290 | [M-H]- | Acetylcaranine | C18H19NO4 | 0.0054 | 0.0011 | 0.0258 | 0.0033 |
| 25 | 8.59 | 301.0335 | 302.0407 | [M-H]- | Quercetin | C15H10O7 | 0.9066 | 0.0009 | ||
| 26 | 9.00 | 431.0985 | 432.1058 | [M-H]- | Apigenin-7-O-glucoside | C21H20O10 | 0.0069 | 0.0003 | ||
| 27 | 9.17 | 809.4290 | 810.4363 | [M-H]- | Azukisaponin III | C42H66O15 | 0.4169 | 0.0582 | ||
| 28 | 9.24 | 315.0506 | 316.0579 | [M-H]- | 6-Methoxy luteolin | C16H12O7 | 0.5725 | 0.0041 | ||
| 29 | 9.99 | 582.2586 | 583.2659 | [M-H]- | Tricoumaroyl spermidine | C34H37N3O6 | 0.0116 | 0.3624 | 0.0034 | 0.0214 |
| 30 | 10.35 | 315.0508 | 316.0580 | [M-H]- | Rhamnetin | C16H12O7 | 1.2297 | 0.0015 | ||
| 31 | 11.70 | 329.2309 | 330.2382 | [M-H]- | 9,10,11-Trihydroxy-(12Z)-12- octadecenoic acid | C18H34O5 | 0.2259 | 0.0448 | 0.6680 | 0.3237 |
| 32 | 14.24 | 247.1339 | 248.1412 | [M-H]- | 3-Hydroxy-14-calamenoic acid | C15H20O3 | 5.1008 | 0.0380 | 0.0034 | 0.005 |
| 33 | 14.25 | 293.1737 | 294.1810 | [M-H]- | Gingerol | C17H26O4 | 0.2933 | 0.3180 | 0.2920 | 0.3002 |
| 34 | 20.49 | 293.2101 | 294.2174 | [M-H]- | Hydroxyoctadectrienoic acid | C18H30O3 | 0.0406 | 0.0096 | 0.0258 | 0.0806 |
| 35 | 25.68 | 253.2149 | 254.2222 | [M-H]- | 9-Hexadecenoic acid | C16H30O2 | 0.0819 | 0.1653 | 0.1796 | 0.0264 |
| 36 | 26.16 | 279.2304 | 280.23773 | [M-H]- | Linoleic acid | C18H32O2 | 0.2374 | 0.4492 | 0.7048 | 2.0156 |
| 37 | 27.42 | 621.4395 | 622.4468 | [M-H]- | Ginsenoside | C36H62O8 | 2.4514 | 0.2084 | ||
| 38 | 27.91 | 255.2308 | 256.2381 | [M-H]- | Palmitic acid | C16H32O2 | 1.5057 | 2.0933 | 2.8938 | 4.1485 |
| 39 | 28.23 | 281.2464 | 282.2536 | [M-H]- | Oleic acid | C18H34O2 | 1.2639 | 1.5673 | 2.0126 | 3.0127 |
| 40 | 29.63 | 311.2242 | 312.2315 | [M-H]- | Octadecenedioic acid | C18H32O4 | 2.6267 | 0.0293 | 0.0002 | 0.0011 |
| 41 | 29.72 | 575.4705 | 576.4778 | [M-H]- | cis-Epoxy octadecenoate | C36H64O5 | 3.1036 | 0.0091 | ||
| 42 | 29.96 | 283.2620 | 284.2693 | [M-H]- | Stearic acid | C18H36O2 | 6.0177 | 8.1601 | 10.6431 | 11.1964 |
| 43 | 30.16 | 409.3085 | 410.3157 | [M-H]- | γ-Tocotrienol | C28H42O2 | 0.4789 | 0.6317 | 0.7026 | 0.5591 |
| 44 | 30.30 | 423.4227 | 424.4299 | [M-H]- | Octacosanoic acid | C28H56O2 | 0.0020 | 0.0003 | 0.0126 | |
| Total relative percentages of the identified compounds | 30.07% | 21.99% | 19.15% | 22.41% | ||||||
| Quantitative Tests Plants | TPC | TFC | TAA | FRAP | DPPH-SA | MCA |
|---|---|---|---|---|---|---|
| Lycium shawii | 52.72 ± 3.17 | 13.01 ± 0.63 | 25.60 ± 4.61 | 56.68 ± 0.62 | 19.76 ± 0.04 | 21.84 ± 0.22 |
| Anabasis articulata | 21.13 ± 0.32 | 11.48 ± 1.52 | 12.43 ± 0.46 | 19.67 ± 0.40 | 7.15 ± 0.46 | 11.89 ± 0.31 |
| Zilla spinosa | 22.36 ± 0.67 | 7.29 ± 0.26 | 14.36 ± 0.38 | 23.68 ± 0.93 | 7.22 ± 0.13 | 13.32 ± 0.58 |
| Rumex vesicarius | 28.54 ± 1.13 | 12.64 ± 0.28 | 10.79 ± 0.46 | 33.09 ± 2.10 | 14.22 ± 0.29 | 13.01 ± 0.09 |
| Cell Lines | Lycium shawii (µg/mL) | Anabasis articulata (µg/mL) | Rumex vesicarius (µg/mL) | Zilla spinosa (µg/mL) |
|---|---|---|---|---|
| MCF-7, IC50 (95% CI) | 194.5 (153.2 to 246.9) | 2030 (944.7 to 4363) | 1759 (661.2 to 4680) | 1077 (661.7 to 1754) |
| K562, IC50 (95% CI) | 464.9 (326.0 to 662.9) | 2729 (1170 to 6366) | 1319 (766.2 to 2270) | 736.9 (475.6 to 1142) |
| PANC-1, IC50 (95% CI) | 2619 (1246 to 5506) | 998.5 (740.9 to 1346) | Not converged | Not converged |
| Fibroblast, IC50 (95% CI) | 3109 (1225 to 7894) | 3659 (1201 to 11,151) | 3139 (1408 to 6999) | 1888 (1105 to 3225) |
| (A) Media Untreated | (B) Half IC50 | (C) IC50 | (D) Double IC50 | |
|---|---|---|---|---|
| Viable Q3 | 64% | 64.3% | 36.2% | 9.5% |
| Early apoptosis Q4 | 0.2% | 1.2% | 2.3% | 0.4% |
| Late apoptosis Q2 | 12.8% | 13.9% | 33.4% | 53.6% |
| Necrosis Q1 | 22.9% | 20.6% | 28.1% | 36.5% |
| Hydroalcoholic Plant Extracts | B. cereus ATCC 10876 | A. niger ATCC 6275 | ||
|---|---|---|---|---|
| MIC (mg/mL) | MBC (mg/mL) | MIC (mg/mL) | MBC (mg/mL) | |
| Lycium shawii | 12.5 | 25 | - | - |
| Anabasis articulata | - | - | 12.5 | 25 |
| Rumex vesicarius | - | - | 50 | 100 |
Publisher’s Note: MDPI stays neutral with regard to jurisdictional claims in published maps and institutional affiliations. |
© 2021 by the authors. Licensee MDPI, Basel, Switzerland. This article is an open access article distributed under the terms and conditions of the Creative Commons Attribution (CC BY) license (https://creativecommons.org/licenses/by/4.0/).
Share and Cite
Mohammed, H.A.; Ali, H.M.; Qureshi, K.A.; Alsharidah, M.; Kandil, Y.I.; Said, R.; Mohammed, S.A.A.; Al-Omar, M.S.; Rugaie, O.A.; Abdellatif, A.A.H.; et al. Comparative Phytochemical Profile and Biological Activity of Four Major Medicinal Halophytes from Qassim Flora. Plants 2021, 10, 2208. https://doi.org/10.3390/plants10102208
Mohammed HA, Ali HM, Qureshi KA, Alsharidah M, Kandil YI, Said R, Mohammed SAA, Al-Omar MS, Rugaie OA, Abdellatif AAH, et al. Comparative Phytochemical Profile and Biological Activity of Four Major Medicinal Halophytes from Qassim Flora. Plants. 2021; 10(10):2208. https://doi.org/10.3390/plants10102208
Chicago/Turabian StyleMohammed, Hamdoon A., Hussein M. Ali, Kamal A. Qureshi, Mansour Alsharidah, Yasser I. Kandil, Rana Said, Salman A. A. Mohammed, Mohsen S. Al-Omar, Osamah Al Rugaie, Ahmed A. H. Abdellatif, and et al. 2021. "Comparative Phytochemical Profile and Biological Activity of Four Major Medicinal Halophytes from Qassim Flora" Plants 10, no. 10: 2208. https://doi.org/10.3390/plants10102208
APA StyleMohammed, H. A., Ali, H. M., Qureshi, K. A., Alsharidah, M., Kandil, Y. I., Said, R., Mohammed, S. A. A., Al-Omar, M. S., Rugaie, O. A., Abdellatif, A. A. H., Abd-Elmoniem, E., Abbas, M. M., Mohany, K. M., & Khan, R. A. (2021). Comparative Phytochemical Profile and Biological Activity of Four Major Medicinal Halophytes from Qassim Flora. Plants, 10(10), 2208. https://doi.org/10.3390/plants10102208










